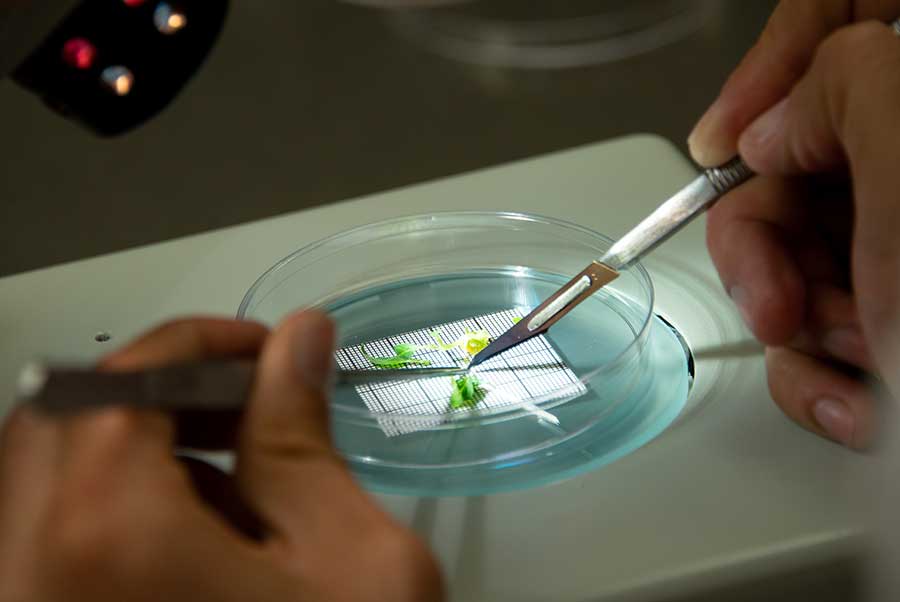

The Huntington’s blog takes you behind the scenes for a scholarly view of the collections.
Strengthening Bonds with Mexico Through Cryopreservation
Posted on Wed., Aug. 7, 2019 by

Huntington Cryopreservation Research Botanist Raquel Folgado supervises as trainees Lourdes Delgado and Felipe de Jesús Romo Paz prepare plant tissue for cryopreservation. Photo by Deborah Miller.
The Huntington has taken a lead role in recent years in the cutting-edge field of plant cryopreservation—the preservation of the seeds, cells, and tissue of plants in extremely low temperatures for long-term storage and conservation. Now, through a program that supports the visits of international visitors to The Huntington's cryopreservation lab, lead scientist Raquel Folgado is sharing her hard-earned knowledge of the field.
This summer, two graduate students from Guadalajara, Mexico are visiting The Huntington for two months, working with Folgado in the lab to learn often difficult cryopreservation techniques they will use on their own projects when they return home.
Delgado dissects a shoot tip from an Agave cerulata plant in The Huntington’s cryopreservation lab. Photo by Deborah Miller.
Lourdes Delgado is a Ph.D. student from the University of Guadalajara working on the management of genetic resources for conservation. Her focus is agave, a plant that is critically important in Mexico for food, the creation of tequila and mezcal, and for construction. (The fibrous material left after processing agave for tequila and mezcal can be used to create a composite material that is stronger than wood.) But agave is under threat. “Mexico is the origin of agave. We have 150 of the 200 known species of agave,” Delgado says. “But more than 10 percent of those are considered endangered.”
Delgado is hoping to learn techniques to cryopreserve agave shoot tips, tiny bits of tissue that, if frozen properly, can later be thawed to give rise to new plants.
The Huntington’s Desert Garden offers many species of agave for Delgado’s experiments. “There’s such an amazing collection here,” Delgado says. “When I saw it, I said, ‘Really? All these plants are here?’” Sadly, many of these Mexican agaves are not accessible at home. “In Mexico, they are not easy to find,” Delgado says. “Many are endangered in the wild, or hard to access. And many have been destroyed.”

Romo places a sample of Agave cerulata plant tissue into liquid nitrogen. Photo by Deborah Miller.
Learning how to freeze plants in liquid nitrogen and then bring them back to life is not easy. But the work has been going well. Agave is relatively easy to work with, Folgado says, because it is a succulent; the plant tolerates the dehydration process that is required for freezing. The experiments Delgado is working on at The Huntington will help her finish her dissertation.
A second student working in the lab is focusing on another important Mexican plant: tomatillo, a key ingredient in both salsas and traditional medicines. Felipe de Jesús Romo Paz is working on a Ph.D. at the University of Guadalajara, looking for ways to make cell lines of tomatillos with desirable traits and to increase their biomass so they can produce more natural chemicals. (Those chemicals may be of use one day as treatments for cancer, obesity, and heart disease, he says.)
“With more biomass, you get more product and more chemicals,” Romo says. “In the lab, we could produce specific chemicals in the plants, using them like a kind of biological factory.” Romo hopes to use the cryopreservation techniques he is learning to clone tomatillo plants with the best traits for mass production.

Lourdes Delgado, left, Raquel Folgado, center, and Felipe de Jesús Romo Paz, taking a break outside the cryopreservation lab. Photo by Deborah Miller.
Folgado, who has led cryopreservation efforts at The Huntington since 2014, has worked with many different plants in that time, but never with tomatillo. “He’s the expert with the plant, and I’m the expert with cryo, so it’s a real exchange,” she says.
Folgado says the training program is one way for The Huntington to strengthen its bonds with Mexico. “The fact that I speak Spanish helps when we’re working in the lab,” she says.
“This specialty of cryopreservation is really rare in the world,” Folgado says. “But we are doing it here, and we’re happy to help others.”
Usha Lee McFarling is senior writer and editor in the Office of Communications and Marketing at The Huntington.